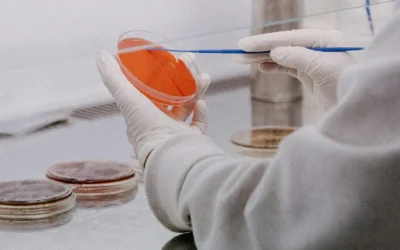
Retatrutide and Cancer Cell Research: What Preclinical Studies Are Showing

Our Best Sellers
Explore All Products
Browse our research-grade peptide reagents for assay development, receptor binding studies, and mechanistic research.
-
Sale!
Tesamorelin
Price range: $60.00 through $1,250.00$60.00A stabilized GHRH analog that stimulates physiologic GH release and IGF-1 elevation, with well-documented effects on visceral adipose…Select options This product has multiple variants. The options may be chosen on the product page -
Sale!
TB500/BPC157
Price range: $70.00 through $800.00$70.00A combination of TB-500’s actin/angiogenesis signaling with BPC-157’s cytoprotection and growth-factor modulation, used in complex injury scenarios.Select options This product has multiple variants. The options may be chosen on the product page -
Semax / Selank (Blend)
$100.00$100.00A combination of Semax (neuroprotective, pro-cognitive) and Selank (anxiolytic, stress-buffering) in one formulation.Add to cart -
Sale!
PT-141 (Bremelanotide)
Price range: $60.00 through $500.00$60.00A central melanocortin MC3/MC4 receptor agonist that acts on hypothalamic and limbic circuits to modulate sexual desire and…Select options This product has multiple variants. The options may be chosen on the product page -
Sale!
KLOW
Price range: $125.00 through $1,000.00$125.00A branded joint and soft-tissue recovery blend, typically incorporating healing and anti-inflammatory peptides (such as BPC-157, TB-500, KPV,…Select options This product has multiple variants. The options may be chosen on the product page -
Sale!
GLOW
Price range: $110.00 through $900.00$110.00A cosmetic-oriented skin and connective-tissue rejuvenation blend, often including peptides like GHK-Cu and BPC-157 plus supportive cofactors.Select options This product has multiple variants. The options may be chosen on the product page
Why Choose Us
Transparency You Can Trust

Every research peptide includes reversed-phase HPLC chromatograms confirming ≥99% purity for reliable laboratory results.
DETAILS
Peptide identity verified by liquid chromatography-mass spectrometry (LC-MS) with documented molecular weight accuracy.
DETAILSAdvantage
What sets us apart
99 Purity Peptides stands on rigorous testing, rapid fulfillment, and direct researcher support. We cut through the noise.



Lab tested and certified
Every compounds passes independent analysis before it reaches your lab. We published the results.

Peptide materials are supplied lyophilized with storage recommendations and reconstitution guidance to maintain stability throughout your research workflow.


Research
Latest Peptide Research Resources
Insights from the lab and the field

Tesamorelin & Visceral Fat: Phase 3 VAT Reduction Data (2026)
Last updated: June 24, 2026Few research peptides have a clinical record as specific as tesamorelin. Across multiple Phase 3 trials, the tesamorelin visceral fat reduction percentage has been measured directly with CT imaging, and the results are remarkably consistent....
Tesamorelin & Visceral Fat: Phase 3 VAT Reduction Data (2026)
Last updated: June 24, 2026Few research peptides have a clinical record as specific as...
Tesamorelin & Visceral Fat: Phase 3 VAT Reduction Data (2026)
Last updated: June 24, 2026Few research peptides have a clinical record as specific as...
Collagen Peptides vs. Peptide Therapy for Skin: What Women Need to Know About Supporting Skin Appearance and Healthy Aging
Last updated: June 16, 2026Quick answer Collagen peptides and peptide therapy are two different...
KLOW Peptide Blend: 2026 Research Guide, Benefits & Dosage
Last updated: May 27, 2026Introduction KLOW peptide is a branded four-component research...
Retatrutide for Weight Loss: 2026 Research Reference
Last updated: May 27, 2026Introduction Retatrutide weight loss research entered a new phase...
GHK-Cu Peptide: Complete Research Guide 2026
Last updated: May 27, 2026Introduction GHK-Cu peptide — the copper complex of...
Retatrutide Peptide: 2026 Research Reference Guide
Last Updated: May 2026 Introduction Retatrutide peptide, identified in the scientific...
Collagen Peptides Benefits: What the Research Actually Shows in 2026
Last Updated: May 2026Introduction Collagen peptides benefits have become one of the most searched...
The Ultimate Peptide Calculator Guide: How to Accurately Reconstitute Research Peptide Vials (U.S. Lab Protocols)
Last Updated: May 2026Every researcher working with peptides faces the same critical challenge:...
Retatrutide and Carbs: Does This Triple Agonist Need Glucose?
Last Updated: May 2026 Retatrutide is emerging as one of the most mechanistically complex peptides...
Reconstituted Peptide Stability: What Laboratory Research Shows
Last Updated: May 2026Accurate peptide calculator results in seconds. Enter your vial size,...
What Are Research Peptides? A Complete Guide for Laboratory Studies (2026)
What Are Research Peptides? A Complete Guide for Laboratory Studies (2026) Research peptides are...
Top Peptides For Metabolic Studies
The field of peptides for metabolic research continues to expand as scientists investigate how...
Tesamorelin and Visceral Fat: What the Research Shows
Not all fat is created equal. While subcutaneous fat — the kind you can pinch beneath the skin —...
Retatrutide and Cancer Cell Research: What Preclinical Studies Are Showing
Retatrutide (LY3437943) entered the research spotlight as a triple-receptor agonist targeting...
Best Practices for Storing Research Peptides in Laboratories
Introduction Proper storage of research peptides is critical for maintaining molecular integrity,...
Tesamorelin and Visceral Fat: What the Research Shows
Not all fat is created equal. While subcutaneous fat — the kind you can pinch beneath the skin —...
Retatrutide and Cancer Cell Research: What Preclinical Studies Are Showing
Retatrutide (LY3437943) entered the research spotlight as a triple-receptor agonist targeting...
Best Practices for Storing Research Peptides in Laboratories
Introduction Proper storage of research peptides is critical for maintaining molecular integrity,...
What Are Research Peptides? A Complete Guide for Laboratory Studies (2026)
What Are Research Peptides? A Complete Guide for Laboratory Studies (2026) Research peptides are...
Top Peptides For Metabolic Studies
The field of peptides for metabolic research continues to expand as scientists investigate how...
Advantage
What sets us apart
99PurityPeptides specializes in high-purity synthetic peptides engineered specifically for research laboratory environments. Our commitment to analytical rigor and documentation transparency addresses the core needs of scientific research:
requirements.
Questions
Still have Questions?
Our technical support team assists research laboratories with peptide selection, COA interpretation, handling recommendations, and application-specific guidance. Whether you’re developing assays, validating analytical methods, or conducting mechanistic studies, we provide the expertise to support your research objectives.